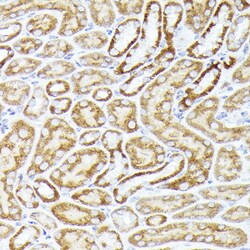
Invitrogen CDw293 Polyclonal Antibody 100 &mu;L; Unconjugated:Antibodies,

Learn More
Invitrogen™ CDw293 Polyclonal Antibody


Rabbit Polyclonal Antibody
Brand: Invitrogen™ PA5120683
Description
Positive test controls include: 293T, HeLa, SH-SY5Y. The target is usually found in the following locations: Membrane, Single-pass type I membrane protein. Immunogen sequence: MLLRSAGKLN VGTKKEDGES TAPTPRPKVL RCKCHHHCPE DSVNNICSTD GYCFTMIEED DSGLPVVTSG CLGLEGSDFQ CRDTPIPHQR RSIECCTERN ECNKDLHPTL PPLKNRDFVD GPIHHR.
BMPR1B (also known as ALK6, CDw293) is a member of the transmembrane serine/threonine kinase that is the member of the bone morphogenetic protein (BMP) receptor, which is closely related to the activin receptors, ACVR1 and ACVR2. BMPR1B is mainly involved in the endochondral bone formation and embryogenesis. BMPR1B expressed in normal and cancerous prostate tissues and used in the endocrine therapy that given to the prostate cancer patients. BMPR1B receptor trafficking also play a significant role in FOP pathogenesis and used in human T-cell differentiation.
Specifications
| CDw293 | |
| Polyclonal | |
| Unconjugated | |
| BMPR1B | |
| Activin receptor-like kinase 6; Acvrlk6; AI385617; Alk6; ALK-6; AMDD; AV355320; BDA1D; BDA2; BMP type-1B receptor; BMP15; Bmpr1b; BMPR-1B; BMPRIB; BMPR-IB; bone morphogenetic protein binding serine/threonine kinase receptor; bone morphogenetic protein receptor IB; bone morphogenetic protein receptor type 1B; bone morphogenetic protein receptor type IB; bone morphogenetic protein receptor type-1B; bone morphogenetic protein receptor, type 1B; bone morphogenetic protein receptor, type IB; CDw293; CFK-43a; serine/threonine receptor kinase; serine/threonine-protein kinase receptor R6; SKR6 | |
| Rabbit | |
| Affinity Chromatography | |
| RUO | |
| 12167, 310914, 658 | |
| -20°C, Avoid Freeze/Thaw Cycles | |
| Liquid |
| ELISA, Immunohistochemistry (Paraffin), Western Blot, Immunocytochemistry | |
| 0.53 mg/mL | |
| PBS with 50% glycerol and 0.05% ProClin 300; pH 7.3 | |
| O00238, P36898 | |
| BMPR1B | |
| Recombinant protein (or fragment). | |
| 100 μL | |
| Primary | |
| Human, Mouse, Rat | |
| Antibody | |
| IgG |
Your input is important to us. Please complete this form to provide feedback related to the content on this product.